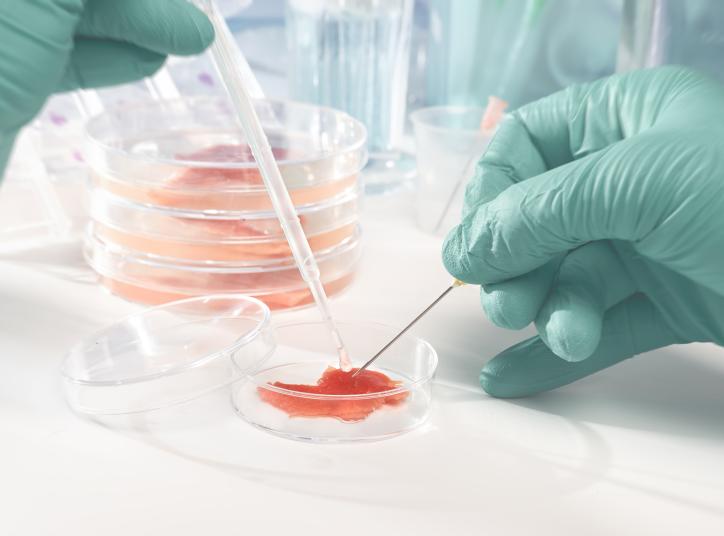
Artificial

|
||||||
Higiene de les citacions |
|
|
|
|
IA i Recerca |
|
||
Convocatòries a Revistes |
|
|
||||||||||||
Agenda, Formació, Premis... |
|
|
|
Informacions d'interés |
|
||||
Butlletins amics |

|
||




|
||
|
De conformitat amb el Reglament (UE) 2016/679, del 27 d'abril de Protecció de Dades Personals (RGPD), l'informem que les seves dades personals es troben en una base de dades titularitat de la Fundació Blanquerna. Vostè té dret a sol·licitar a la Fundació Blanquerna l'accés a les seves dades personals així com a la seva rectificació, supressió si s'escau i a la limitació del seu tractament. En aquest cas li estem enviant el RecercaBlanquerna. Si vol deixar de rebre'l enviï un correu electrònic a rgpd@blanquerna.edu explicitant que ja no el vol rebre amb l'assumpte "Baixa de RecercaBlanquerna". |
||